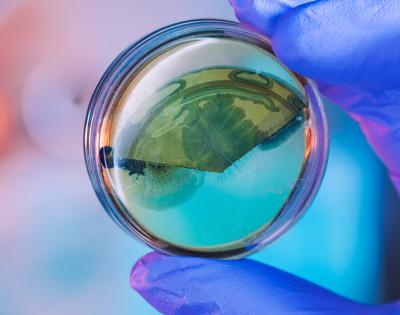

School of Medicine
From driving cutting-edge research to bringing medical innovations to market, landing competitive awards and more, the faculty, staff and students at Case Western Reserve University School of Medicine know how to make headlines.

Getty Images
Hero Type
Image
Biophysics’ Walter F. Boron receives the 2025 Christian Bohr Prize
Walter F. Boron, Distinguished University Professor and the David N. and Inez Myers/Antonio Scarpa Professor in the Department of Physiology and Biophysics at Case Western Reserve University School of Medicine, recently was awarded the Scandinavian Physiological Society's 2025 Christian Bohr Prize…
Recent News

October 20, 2025
Each year, up to 90 distinguished professionals in health and medicine from the U.S. are recognized for their contributions to the field by being elected to join the National Academy of Medicine, an esteemed organization that provides advice to improve medicine and biomedical science by addressing…

October 20, 2025
Study shows corneas from donors with diabetes are just as effective for surgery

October 15, 2025
When J. Alan Diehl arrived at Case Western Reserve University in 2019, the Department of Biochemistry in the School of Medicine was at a crossroads—ready for a renewed sense of purpose and direction. Six years later, under Diehl’s leadership as chair, the department’s faculty headcount has more…

October 10, 2025
From the excitement of receiving a white coat to the challenges of clinical rotations and the anticipation of Match Day, every medical journey is unique. At Case Western Reserve University, these moments—big and small—come together to tell the remarkable stories of students with invaluable…

October 10, 2025
The Clinical and Translational Science Collaborative (CTSC) of Northern Ohio recently announced Ian J. Neeland—associate professor of medicine at Case Western Reserve University—as co-lead for the pilot program and research program proposals. A nationally recognized cardiologist and clinical…

October 07, 2025
The University Program Board (UPB) brings large-scale events such as the Back to School Bash to life each year, with a team of students making it all happen. One such student is Harini Ganapathy, a fourth-year student double-majoring in neuroscience and psychology and vice president of…

October 06, 2025
When Eileen Anderson, director of education for Case Western Reserve University’s bioethics and medical humanities programs, first encountered the court system during a divorce, she learned about the role of a guardian ad litem—an individual appointed to represent a child’s best interest in legal…
October 03, 2025
Jacob Scott, professor of radiation oncology at Case Western Reserve University School of Medicine, recently was published in the Proceedings of the National Academy of Sciences (PNAS) for his research related to bacterial evolution. The article, titled “Evolution under vancomycin selection…

September 29, 2025
For over three decades, HIV has played an elaborate game of hide-and-seek with researchers, making treating—and possibly even curing—the disease a seemingly insurmountable obstacle to achieve. But scientists at Case Western Reserve University have made a breakthrough discovery that could…

September 26, 2025
Walter F. Boron, Distinguished University Professor and the David N. and Inez Myers/Antonio Scarpa Professor in the Department of Physiology and Biophysics at Case Western Reserve University School of Medicine, recently was awarded the Scandinavian Physiological Society's 2025 Christian Bohr Prize.…